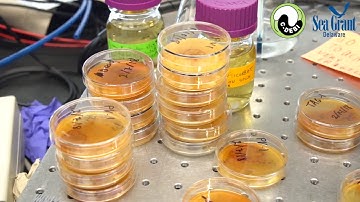
Dive Deeper - Iron-Oxidizing Bacteria

⬇ DOWNLOAD NOW
Kalau muncul iklan pop-up, tutup lalu klik tombol kembali
Download lagu Microbial Feast: Deep Dive into Phosphate & Iron secara gratis hanya untuk keperluan promosi. Dukung artis favorit kamu dengan membeli musik original di iTunes atau platform resmi lainnya.
 Microorganisms | The Dr. Binocs Show | Educational Videos For Kids
Microorganisms | The Dr. Binocs Show | Educational Videos For Kids
 Grade 12 Biology Unit 2: Microorganisms Explained | Types, Uses, and Importance in Our Lives 🦠✨
Grade 12 Biology Unit 2: Microorganisms Explained | Types, Uses, and Importance in Our Lives 🦠✨
 Microbiomes in food systems | MicrobiomeSupport
Microbiomes in food systems | MicrobiomeSupport
 DEEP DIVE: The Phosphorus Cycle In Freshwater Aquariums & Ecosystems. Phosphates, Plants & Algae!
DEEP DIVE: The Phosphorus Cycle In Freshwater Aquariums & Ecosystems. Phosphates, Plants & Algae!
 Microbial iron cycling in biogeochemical cycles past and present: Casey Bryce
Microbial iron cycling in biogeochemical cycles past and present: Casey Bryce
Dive Deeper - Iron-Oxidizing Bacteria
Dive Deeper - Iron-Oxidizing Bacteria
 Agar plate streaking
Agar plate streaking
 Microscopic Marvels A Deep Dive into Microorganisms
Microscopic Marvels A Deep Dive into Microorganisms